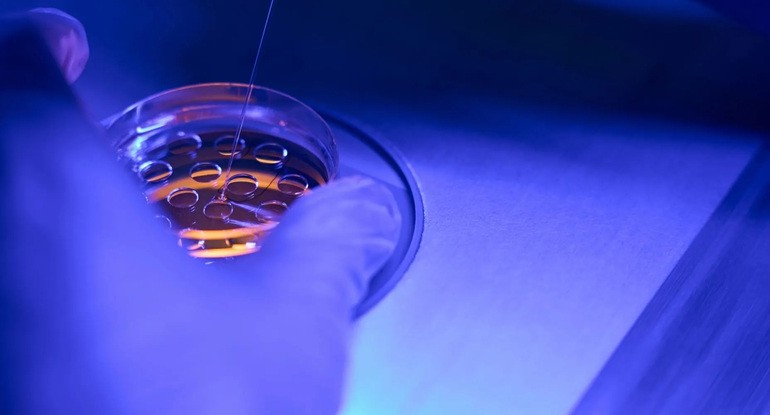

A inteligência artificial (IA) vem transformando, cada vez mais, a medicina reprodutiva. Se, no início, ela era vista apenas como um recurso de análise de dados, hoje já está presente em etapas decisivas da fertilização in vitro (FIV), desde a…

A inteligência artificial (IA) vem transformando, cada vez mais, a medicina reprodutiva. Se, no início, ela era vista apenas como um recurso de análise de dados, hoje já está presente em etapas decisivas da fertilização in vitro (FIV), desde a…

A partir desta segunda-feira (1º/9), o implante contraceptivo hormonal Implanon passa a ser de cobertura obrigatória pelos planos de saúde. A determinação é válida para pessoas com idades entre 18 e 49 anos. O dispositivo, com tamanho aproximado ao de um…

A “adoção” de embriões é uma possibilidade real para pessoas que sonham em gestar um bebê, mas não podem recorrer a embriões próprios. A prática ocorre quando casais que passaram por tratamentos de fertilização in vitro (FIV) compartilham embriões…

No mês em que se celebra o Dia dos Pais, o foco geralmente recai sobre histórias de afeto e presença. Mas para muitos homens, essa data também desperta um desejo que ainda não se concretizou: o de se construir família.…

Quando o bebê nasce e é colocado ao seio pela primeira vez, um processo impressionante entra em ação dentro do corpo da mãe. O que parece um simples ato instintivo de nutrição é, na verdade, resultado de uma complexa…

Por mais que, para muitas pessoas, amar e cuidar do seu parceiro lembre coisas como presentes, jantares românticos e momentos especiais a dois, há também outras questões muito importantes em um relacionamento. É o caso da saúde íntima, e cuidar…

Vamberto Maia Filho, ginecologista e especialista em reprodução humana, alerta para sintomas e fala de diagnóstico multidisciplinar e tratamento personalizado No último dia 2, o Senado aprovou o Projeto de Lei nº 3.010/2019. Ele equipara pessoas com fibromialgia, assim como…

O intervalo entre uma gestação e outra pode variar bastante. Há mulheres que optam por esperar alguns anos antes de ter outro bebê. Outras engravidam enquanto ainda estão amamentando o filho mais velho. Independentemente da circunstância, essas situações fazem…

A cada ciclo menstrual, a reserva de óvulos das mulheres reduz. No entanto, uma parcela significativa delas desconhece que a partir dos 35 anos a fertilidade começa a declinar de forma mais acentuada, o que pode tornar o processo de engravidar naturalmente mais difícil.…

Lá pelos anos 1980 e 1990, quando muitas de nós nascemos, era comum que as mulheres se tornassem mães antes dos 30 anos. No entanto, com o avanço da presença feminina no mercado de trabalho e outras conquistas sociais,…